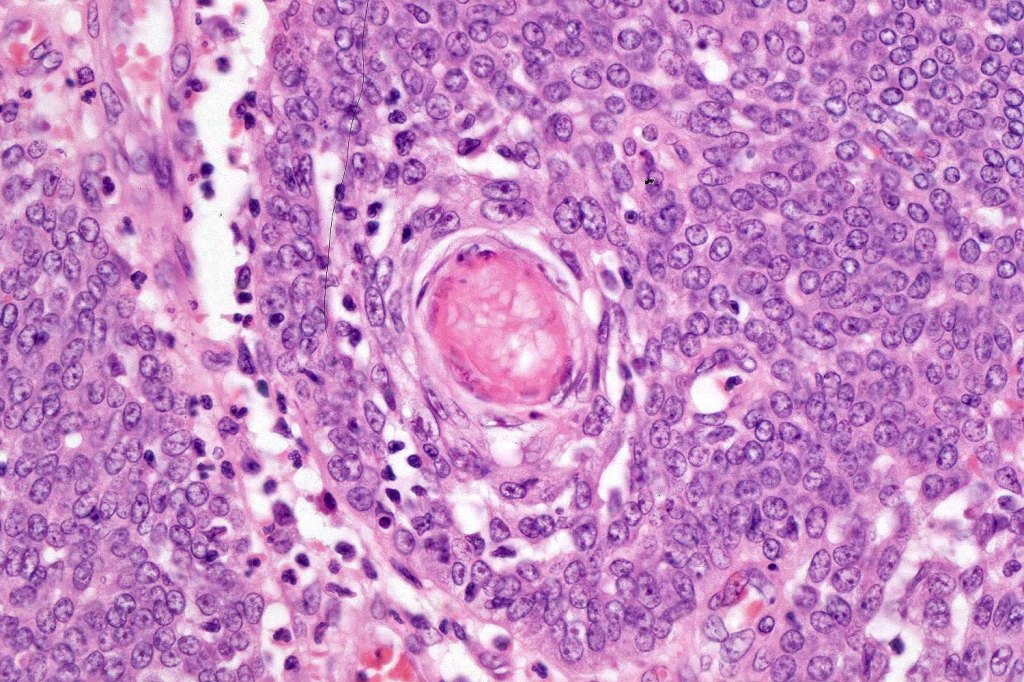
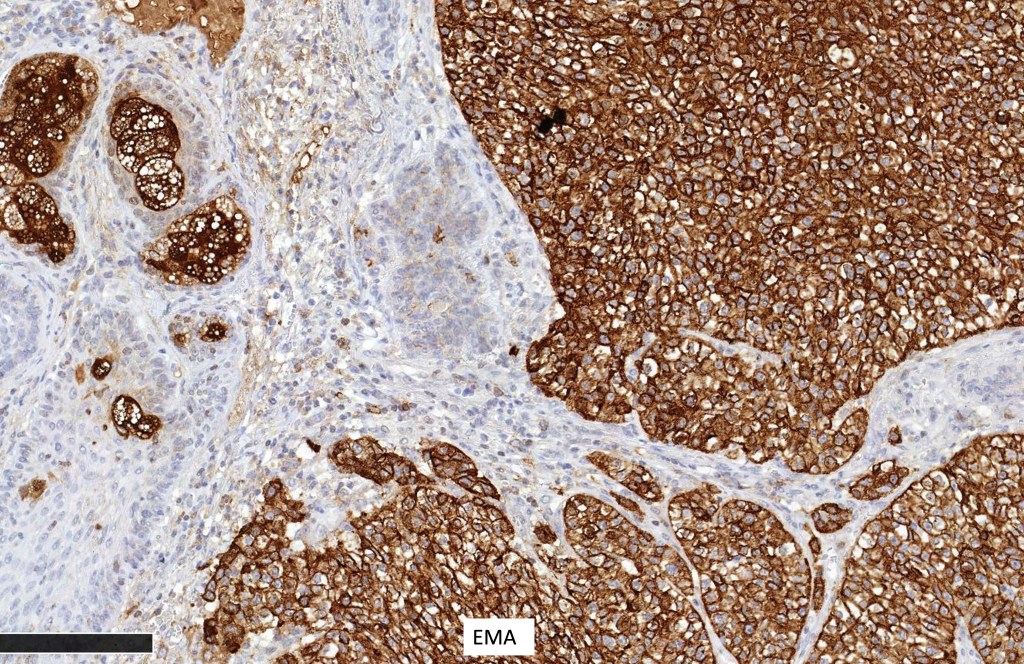
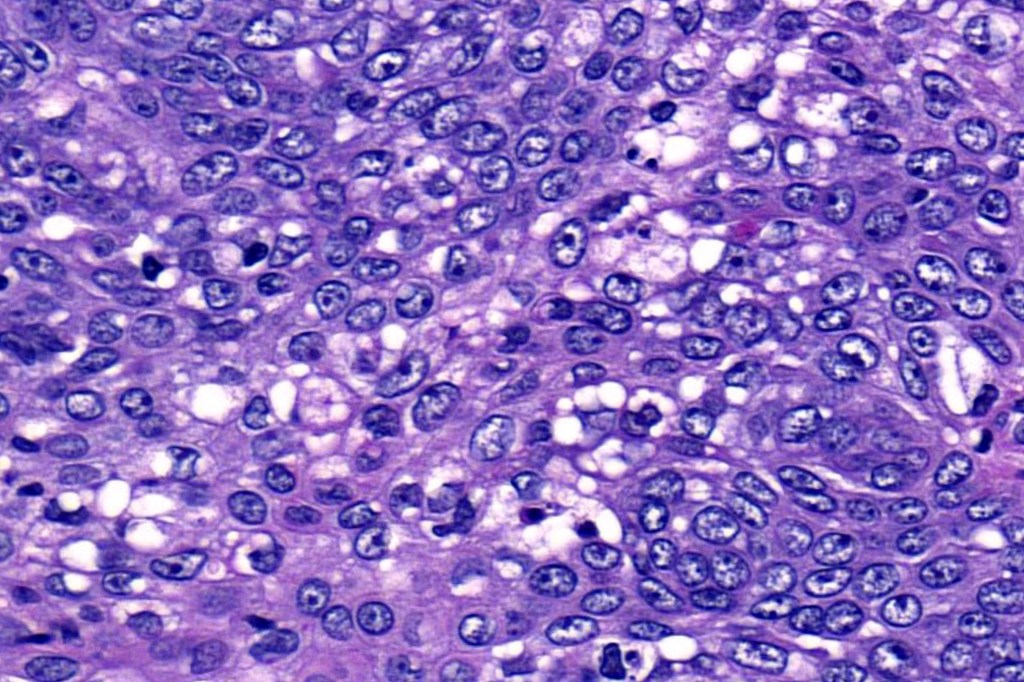

Clinical features
•Although often classified as periocular or extraocular, this has little merit since there is no difference between the two groups in terms of overall survival
•Periocular tumors mostly arise from the meibomian glands and present as a mass in the upper eyelid
•Extraocular tumors most often present on the head and neck although they may arise in a very wide variety of sites.
•Extraocular tumors present as nodulocystic lesions or plaques often with a yellow-red color & variably ulcerated
•Exceptionally complicates nevus sebaceus
•Exceptionally tumors develop in the oral cavity & hypopharynx, bronchus, breast, lung, parotid gland, cervix & within ovarian teratoma
•Sebaceous carcinoma may be a manifestation of Muir-Torre syndrome particularly those arising in outside the head and neck
Histological features
•Well differentiated lobular growth pattern though to a poorly differentiated tumor often showing a diffuse, infiltrating border which may extend into the subcutaneous fat
•Peripheral palisading with retraction artifact and mucin deposition as seen in basal cell carcinoma is not present
•Comedo type necrosis commonly present
•May be associated with Pagetoid spread
•Well differentiated examples can be deceptive unless one looks carefully for pleomorphism, necrosis, excessive mitotic activity and abnormal mitoses. Be careful diagnosing sebaceous adenoma, particularly large examples arising in the elderly
•Periocular shave biopsies can be misleading and easily mistaken for Bowen’s disease
•Tumors are composed of an admixture of darkly staining basaloid cells with hyperchromatic or vesicular nuclei and more obvious sebaceous cells with eosinophilic, bubbly, multivacuolated cytoplasm frequently indenting the nucleus (scalloped)
•Often mitoses are numerous and abnormal forms evident
•Variable Lymphovascular invasion & perineural infiltration
•Focal squamous differentiation with keratinization can be present resulting in confusion with squamous cell carcinoma
•Ripple pattern variant
•Associated apocrine differentiation
•Frozen section-stained tumor cell lipid can be highlighted with Oil Red O
•May be graded into well, moderate & poorly differentiated categories. I am not sure that this has any great value

Sebaceous carcinoma from a patient with Muir-Torre syndrome kindly shared by Dr. Antonina Kalmykova.








Immunohistochemistry (from the Muir-Torre patient except for EMA which was shared by Dr. Tsheri Dorji

If you enjoy this blog, please subscribe and hit the like button. This is very important to me. These blogs are not static or cast in stone. If you have relevant comments, these can be added. Similarly, if you have additional cases that you would like to contribute, please email me on phmckee1948@gmail.com. Please note that only well-stained, perfectly focused and high resolution images can be considered.
Leave a comment